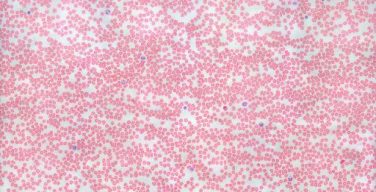

El pasado miércoles 20 de febrero el alumnado de 4º de la...
Author :
Nuestro alumnado de 3ºESO realizó una actividad de lo más interesante, que...
Desde la implantación de los iPADs en nuestro centro, el profesorado viene...
El pasado lunes 21 y jueves 24 de Enero, los alumnos de...
Durante el pasado día viernes 18 de Enero el alumnado de 3º de ESO,...
El viernes 30 de noviembre el grupo de 2º de Bachillerato realizó...